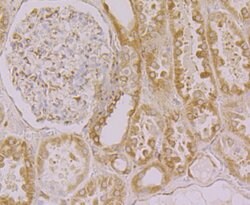
Invitrogen Calnexin Polyclonal Antibody 100 &mu;L; Unconjugated:Antibodies,

missing translation for 'onlineSavingsMsg'
Learn More
Learn More
Invitrogen™ Calnexin Polyclonal Antibody


Description
Positive Control: Daudi, mouse lung tissue, human colon tissue, human breast cancer tissue, human kidney tissue, mouse testis tissue, SKOV-3. Subcellular Location: Endoplasmic reticulum.
Calnexin, also referred to as IP90, p88 and p90, is an approximately 90 kDa integral membrane protein of the endoplasmic reticulum (ER). Many resident ER proteins act as molecular chaperones and participate in the proper folding of polypeptides and their assembly into multisubunit proteins. Studies indicate that calnexin associates with the major histocompatibility complex (MHC) class I heavy chains, partial complexes of the T cell receptor and B cell membrane immunoglobulin, but not with completed receptor complexes. It has been shown that calnexin is a chaperone that retains incompletely or improperly folded proteins in the ER. The sequence Lys-Asp-Glu-Leu (KDEL) or a closely related sequence, is present at the carboxy-terminus of soluble ER resident proteins such as GRP78 and GRP94 and protein disulfide isomerase. Integral membrane ER resident proteins, like calnexin, often lack this KDEL sequence but contain positively charged cytosolic residues that ensure ER retention. Calnexin contains a large ER luminal domain (461 amino acids), a transmembrane segment (22 amino acids), and a cytoplasmic tail (89 amino acids).

Specifications
Specifications
| Antigen | Calnexin |
| Applications | Flow Cytometry, Immunohistochemistry (Paraffin), Western Blot |
| Classification | Polyclonal |
| Concentration | 1 mg/mL |
| Conjugate | Unconjugated |
| Formulation | PBS with 50% glycerol, 0.2% BSA and 0.05% sodium azide; pH 7.4 |
| Gene | CANX |
| Gene Accession No. | P27824, P35564, P35565 |
| Gene Alias | 1110069N15Rik; AI988026; calmegin; calnexin; canx; canx-a; canx-b; clgn; clnx; cnx; D11Ertd153e; FLJ26570; hypothetical protein; IP90; Major histocompatibility complex class I antigen-binding protein p88; p88; P90; PP90; pp90 precursor |
| Gene Symbols | CANX |
| Show More |
Product Title
By clicking Submit, you acknowledge that you may be contacted by Fisher Scientific in regards to the feedback you have provided in this form. We will not share your information for any other purposes. All contact information provided shall also be maintained in accordance with our Privacy Policy.
Spot an opportunity for improvement?